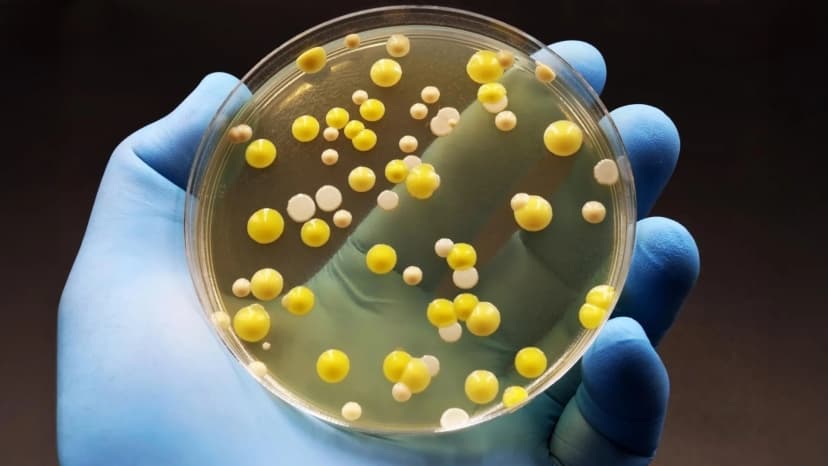
Graphene Kills Superbugs, Safe for Humans

Home / Science / Graphene Kills Superbugs, Safe for Humans
Graphene Kills Superbugs, Safe for Humans
26 Apr
Summary
- Graphene oxide selectively targets bacteria by disrupting membranes.
- The material is effective against antibiotic-resistant superbugs.
- Graphene-based products, including toothbrushes, are already commercialized.
Researchers have detailed the mechanism by which graphene oxide (GO) exerts its antibacterial effects, offering a new path for safe, non-antibiotic antibacterial materials. GO, a single atomic layer of carbon with attached oxygen groups, selectively targets and disrupts bacterial cell membranes.
This selectivity is attributed to oxygen-containing groups on GO, which bind specifically to POPG, a molecule present in bacterial membranes but absent in human cells. This precise interaction allows GO to break down bacterial structures without harming human tissues.
When applied in nanofiber form, GO effectively inhibits a wide spectrum of bacteria, including dangerous superbugs. In animal tests, it accelerated wound healing and reduced inflammation. Furthermore, graphene oxide fibers retained their antibacterial properties even after repeated washing, indicating their suitability for textiles.
The technology has already seen commercial success, with a graphene antibacterial toothbrush selling over 10 million units. Additionally, GrapheneTex, a textile material, was featured in uniforms for the 2024 Paris Olympics Taekwondo demonstration team and is slated for use in future sporting events.